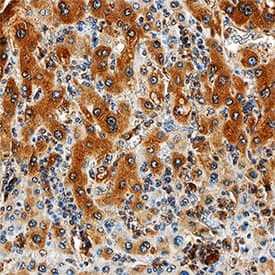
MMP-1 antibody in Human Liver by Immunohistochemistry (IHC-P).

Human MMP-1 Antibody
R&D Systems, part of Bio-Techne | Catalog # MAB901R


Key Product Details
Validated by
Species Reactivity
Validated:
Cited:
Applications
Validated:
Cited:
Label
Antibody Source
Product Specifications
Immunogen
Phe20-Asn469
Accession # P03956
Specificity
Clonality
Host
Isotype
Scientific Data Images for Human MMP-1 Antibody
Detection of Human MMP‑1 by Western Blot.
Western blot shows lysates of IMR-90 human lung fibroblast cell line and PC-3 human prostate cancer cell line. PVDF membrane was probed with 2 µg/mL of Recombinant Mouse Anti-Human MMP-1 Monoclonal Antibody (Catalog # MAB901R) followed by HRP-conjugated Anti-Mouse IgG Secondary Antibody (Catalog # HAF018). A specific band was detected for MMP-1 at approximately 50 kDa (as indicated). This experiment was conducted under reducing conditions and using Immunoblot Buffer Group 1.MMP‑1 in Human Liver.
MMP-1 was detected in immersion fixed paraffin-embedded sections of human liver using Recombinant Mouse Anti-Human MMP-1 Monoclonal Antibody (Catalog # MAB901R) at 15 µg/mL overnight at 4 °C. Tissue was stained using the Anti-Mouse HRP-DAB Cell & Tissue Staining Kit (brown; Catalog # CTS002) and counterstained with hematoxylin (blue). Specific staining was localized to cytoplasm in hepatocytes. View our protocol for Chromogenic IHC Staining of Paraffin-embedded Tissue Sections.Western Blot Shows Human MMP‑1 Specificity by Using Knockout Cell Line.
Western blot shows lysates of PC-3 human prostate cancer parental cell line and MMP-1 knockout PC-3 cell line (KO). PVDF membrane was probed with 2 µg/mL of Mouse Anti-Human MMP-1 Monoclonal Antibody (Catalog # MAB901R) followed by HRP-conjugated Anti-Mouse IgG Secondary Antibody (Catalog # HAF018). A specific band was detected for MMP-1 at approximately 50 kDa (as indicated) in the parental PC-3 cell line, but is not detectable in knockout PC-3 cell line. GAPDH (Catalog # AF5718) is shown as a loading control. This experiment was conducted under reducing conditions and using Immunoblot Buffer Group 1.Applications for Human MMP-1 Antibody
Immunohistochemistry
Sample: Immersion fixed paraffin-embedded sections of human liver
Knockout Validated
Western Blot
Sample: IMR‑90 human lung fibroblast cell line and PC‑3 human prostate cancer cell line
Formulation, Preparation, and Storage
Purification
Reconstitution
Formulation
Shipping
Stability & Storage
Background: MMP-1
Matrix metalloproteinases are a family of zinc and calcium dependent endopeptidases with the combined ability to degrade all the components of the extracellular matrix. MMP-1 (interstitial collagenase), can degrade a broad range of substrates including types I, II, III, VII, VIII, and X collagens as well as casein, gelatin, alpha‑1 antitrypsin, myelin basic protein, L-Selectin, pro-TNF, IL-1 beta, IGF-BP3, IGF-BP5, pro MMP-2 and pro MMP-9. A significant role of MMP-1 is the degradation of fibrillar collagens in extracellular matrix remodeling, characterized by the cleavage of the interstitial collagen triple helix into ¾, ¼ fragments. However, as the list of substrates above illustrates, the role of MMP-1 is more diverse than originally envisaged, and may involve enzyme cascades, cytokine regulation and cell surface molecule modulation. MMP-1 is expressed by fibroblasts, keratinocytes, endothelial cells, monocytes and macrophages. Structurally, MMP-1 may be divided into several distinct domains; a pro-domain which is cleaved upon activation; a catalytic domain containing the zinc binding site; a short hinge region and a carboxyl terminal (hemopexin-like) domain.
References
- Cawston, T.E. (2004) in Interstitial Collagenase. Barrett, A.J. et al. (eds): Handbook of Proteolytic Enzymes, San Diego: Academic Press, p. 472.
Long Name
Alternate Names
Gene Symbol
UniProt
Additional MMP-1 Products
Product Documents for Human MMP-1 Antibody
Product Specific Notices for Human MMP-1 Antibody
For research use only